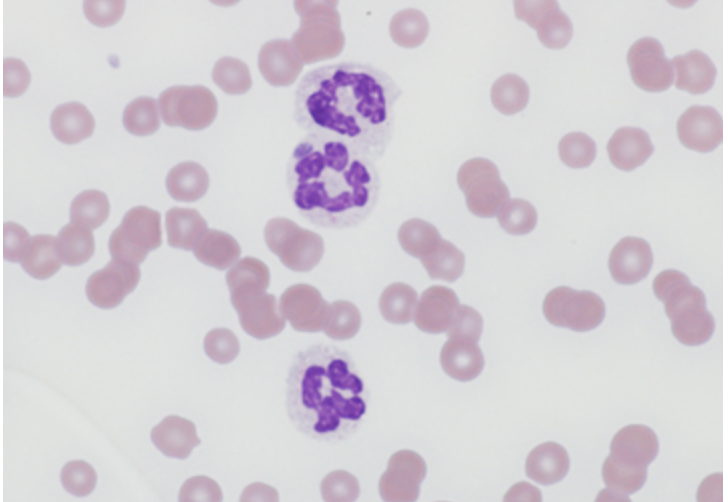

African Horse Sickness
viral respiratory disease of horses but signs are primarily pulmonary. Transmitted by insects, primarily Culicoides. Clinical signs typically develop 5-7 days after infection and begin with fever and conjunctivitis. Some may recover, but many go on to develop the pulmonary and/or cardiac forms of AHS. The pulmonary form consists of acute respiratory distress, coughing, sweating, and foaming from the nostrils; this form is usually fatal. The cardiac form consists of edema of the head and neck as well as abdominal pain and depression. A characteristic sign is swelling in the indentation above the eyes (also referred to as swelling of the supraorbital fossa). About 50% of animals with the cardiac from die fo heart failure while the rest gradually recover after about one week.
Anaplasma phagocytophilum
Equine Granulocytic Ehrlichiosis (formerly Ehrlichi equi)- clinical signs: fever, lethargy, tachycardia and limb edema. Microscopic observation of a morula within the neutrophil. Diagnosis can be supported via PCR assay. Spread via tick bites. Treat with oxytetracyline.
Anhidrosis
The inability to sweat, which can be fatal if not addressed. The cause is unknown. It tends to occur in hot humid climates and may occur in horses raised in the climate or, more commonly, horses brought into the climate. The most successful treatment is to move the horse back to a more favorable climate.
Anoplocephala magna
tapeworm of horse; usually found in the small intestine
Treat with pyrantel salts
involves free-living oribatid mites as intermediate hosts
Anoplocephala perfoliata
tapeworm of horse; usually found in the ileocecal junction
Treat with pyrantel salts
involves free-living oribatid mites as intermediate hosts
Auriculppalpebral nerve block
Disrupts motor to orbiculoris oculi
Bog spavin
fluid distension of the high mobility joint in the hock called the tibiotarsal or tarsocrural joint
Bone spavin
bony growth within the lower hock joint of horse or cattle. It is caused by osteoarthritis, and the degree of lameness that results can be serious enough to end a horse’s competitive career
Borrelia burgdorferi
Lyme Disease
low-grade fever, stiffness and lameness in more than one limb, muscle tenderness, hyperesthesia, swollen joints, lethargy and behavioral changes
oxytetracycline of doxycycline
Burkholderia mallei
Glanders - can be identified on smears make from fresh lesions as mainly extracellular straight gram-negative rods with rounded ends. Diagnostic tests: PCR, ELISA, and western blot but mostly need to know that are used in international trade are complement fixation (CF) serology and the mallein test. Mallein test is considered the most reliable, sensitive and specific. It involves injection of mallein purifies protein derivative intradermally into the lower eyelid. The test is read 24 to 48 hours and a positive reaction is characterized by edematous swelling or purulent discharge. Horse should not be treated; local authorities should be notified if a case is suspected and if disease is confirmed, horses must be humanely destroyed and affected carcasses should be burned and buried. Endemic in regions of the Middle East, Africa, and South America. Affects donkeys, mules, and small ruminants. Horses can become chronic or occult carriers and shed this deadly and potentially zoonotic pathogen.
Buttress foot
also known as pyramidal disease or extensor process disease, arises secondary to excessive strain on the extensor process of P3 resulting in periostitis in the region of the pyramidal process. There is often associated fracture of the process. As the disease progresses, lameness worsens and skin of the cornet band becomes thickened and indurated. In addition, the wall of the hoof protrudes at the toe.
C. pseudotuberculosis test
internal abscesses, hemagglutination inhibition test
Cerebellar Abiotrophy
usually observed in foals which are less than one year of age, particularly 1-6 months of age. It is mostly seen in Arabian, Oldenburg, and Gotland breeds. There is no treatment and signs may be progressive. Diagnosis is based on a good history and clinical signs such as intention tremors, lack of a menace, hypermetria, and ataxia.
Cervical vertebral malformations (Wobbler Syndrome)
Seen primarily in horses under a year of age
Chorioptes equi
mange mite that is usually found around the foot and fetlock. It causes pruritic dermatitis that can cause the formation fo papules, crusts, thickened skin, as well as alopecia. The mites are often found in feathered hair around the fetlock of draft horse. Ivermectin is the treatment of choice.
Chronic hepatitis histopathology
hepatocyte, damage, variable fibrosis, inflammatory infiltration, and evidence of biliary hyperplasia with bile stasis
Chronic seborrheic dermatitis
“scratches” due to wet environment
Club foot
Condition seen in horses secondary to contracture of the distal interphalangeal joint leading to steep hoof wall and shortened toe.
Coggin’s test
EIA - effective in diagnosing infection in chronic asymptomatic carriers, immunodiffusion
Common IM vaccine reaction
Strangles vaccine is associated with a soft tissue reaction, there is now an intra-nasal vaccine available with local protection
Commonly injured when horse flips over backwards
Ruptured longus capitis
Corynebacterium pseudotuberculosis
“Pigeon fever” Causes ulcerative lymphangitis and abscesses in the pectoral region of horses. Treatment is aimed at hot packing the swellings and draining the abscesses. Antibiotic can be administered but have been known to prolong the disease by delay abscess formation.
Culicoides
“sweet itch” Diffuse lesions, recurs seasonally in the warmer months and tends to worsen with age. Occurs due to an allergy to the saliva of the gnat. Pruritic and develop lesions on the poll, mane, and tail from self-trauma, ventral midline dermatitis can occur as well. Decrease exposure to gnats and treat with steroids.
Cutaneous glanders
Also known as Farcy. The cutaneous form develops over several months, beginning with cough and dyspnea as well. Eventually nodules develop in subcutaneous tissue along the course of the lymphatics of the legs, costal areas, and ventrum. They can rupture and excrete infectious purulent exudate. Infected lymphatics may form thickened cord-like lesions that sometimes coalesce into a string of beads appearance know as “farcy pipes.” Nodular lesions of other organs may also be found.


